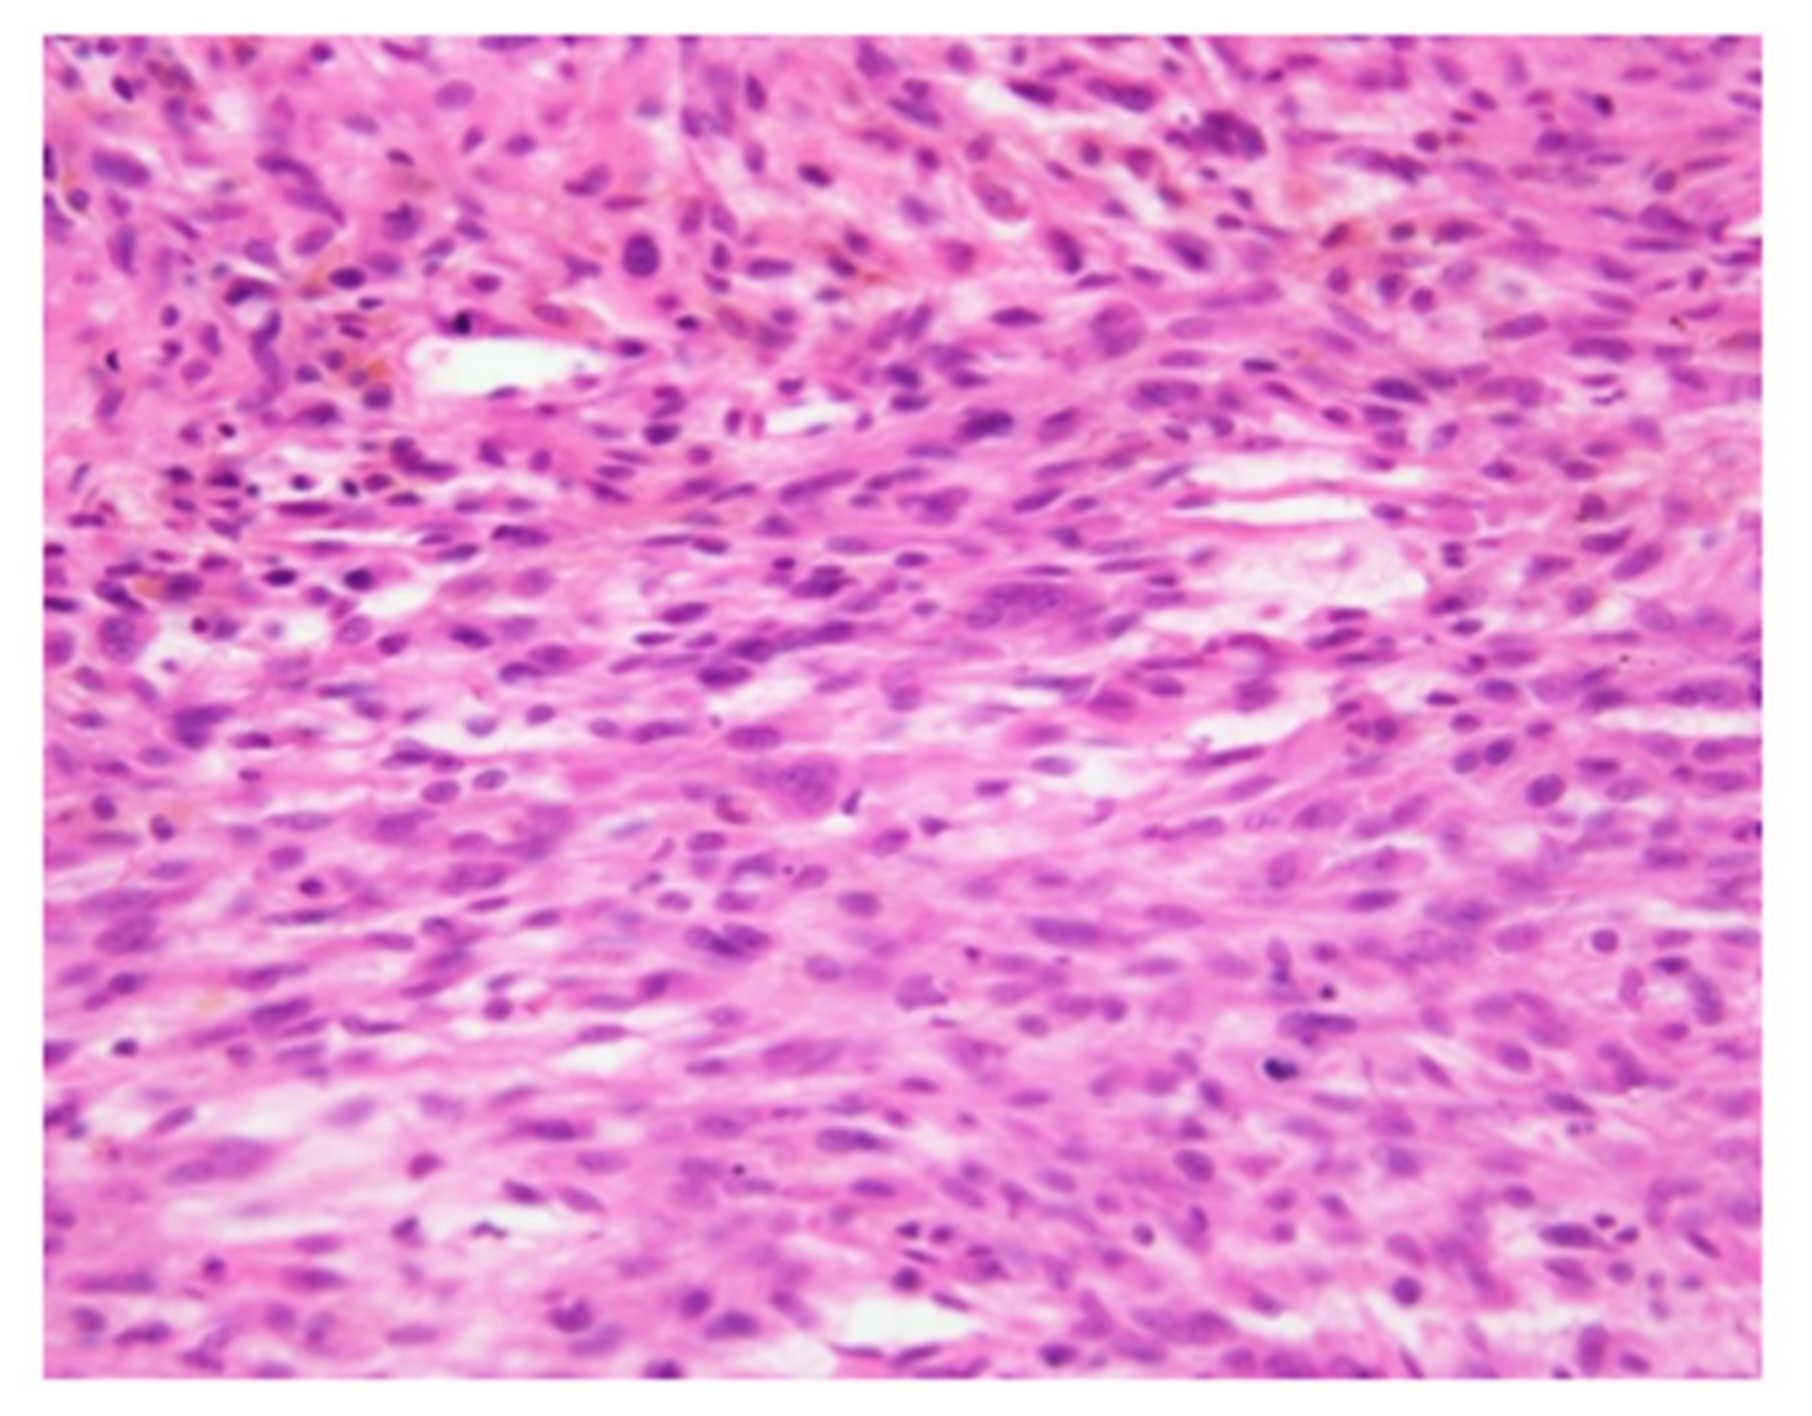
Cancers 11 00506 g002

Treatment of a Malignant Soft Tissue Tumor Arising in the Vicinity of the Sciatic Nerve with an In-Situ Preparation Technique and Intensive Multidisciplinary Therapy
Abstract
:1. Introduction
2. Case Presentation
3. Surgical Procedure
4. Postoperative Course
5. Discussion
6. Conclusions
Author Contributions
Funding
Acknowledgments
Conflicts of Interest
Appendix A


References
- Matsumoto, S.; Kawaguchi, N.; Manabe, J.; Matsushita, Y. “In situ preparation”: New surgical procedure indicated for soft-tissue sarcoma of a lower limb in close proximity to major neurovascular structures. Int. J. Clin. Oncol. 2002, 7, 51–56. [Google Scholar]
- Aiba, H.; Yamada, S.; Mizutani, J.; Yamamoto, N.; Okamoto, H.; Hayashi, K.; Takeuchi, A.; Miwa, S.; Higuchi, T.; Abe, K.; et al. Efficacy of radio-hyperthermo-chemotherapy as salvage therapy for recurrent or residual malignant soft tissue tumors. Int. J. Hyperthermia. 2018, 35, 658–666. [Google Scholar] [CrossRef] [PubMed]
- Aiba, H.; Yamada, S.; Mizutani, J.; Yamamoto, N.; Okamoto, H.; Hayashi, K.; Kimura, H.; Takeuchi, A.; Miwa, S.; Higuchi, T.; et al. Preoperative evaluation of the efficacy of radio-hyperthermo-chemotherapy for soft tissue sarcoma in a case series. PLoS ONE 2018, 13, e0195289. [Google Scholar] [CrossRef] [PubMed]
- Aiba, H.; Yamada, S.; Mizutani, J.; Yamamoto, N.; Okamoto, H.; Hayashi, K.; Kimura, H.; Takeuchi, A.; Miwa, S.; Kawai, A.; et al. Clinical outcomes of radio-hyperthermo-chemotherapy for soft tissue sarcoma compared to a soft tissue sarcoma registry in Japan: A retrospective matched-pair cohort study. Cancer Med. 2018, 4, 1560–1571. [Google Scholar] [CrossRef] [PubMed]
- Ohtomo, K.; Terui, S.; Yokoyama, R.; Abe, H.; Terauchi, T.; Maeda, G.; Beppu, Y.; Fukuma, H. Thallium-201 scintigraphy to assess effect of chemotherapy in osteosarcoma. J. Nucl. Med. 1996, 37, 1444–1448. [Google Scholar] [PubMed]
- Tirkes, T.; Hollar, M.A.; Tann, M.; Kohli, M.D.; Akisik, F.; Sandrasegaran, K. Response criteria in oncologic imaging: Review of traditional and new criteria. Radiographics 2013, 33, 1323–1341. [Google Scholar] [CrossRef] [PubMed]
- Younge, D.; Paramasivan, O.N. Transtibial Amputation for Sciatic Nerve Loss; Saphenous Sensate Residual Limb. Clin. Orthop. Relat. Res. 1998, 347, 200–202. [Google Scholar] [CrossRef]
- Bickels, J.; Wittig, J.C.; Kollender, Y.; Kellar-Graney, K.; Malawer, M.M.; Meller, I. Sciatic nerve resection: Is that truly an indication for amputation? Clin. Orthop. Relat. Res. 2002, 399, 201–204. [Google Scholar] [CrossRef]
- Brennan, M.F. Soft tissue sarcoma involving the sciatic nerve. Br. J. Surg. 2000, 87, 983. [Google Scholar] [CrossRef] [PubMed]
- Fuchs, B.; Davis, A.M.; Wunder, J.S.; Bell, R.S.; Masri, B.A.; Isler, M.; Turcotte, R.; Rock, M.G. Sciatic nerve resection in the thigh: A functional evaluation. Clin. Orthop. Relat. Res. 2001, 382, 34–41. [Google Scholar] [CrossRef]
- Matsumoto, S.; Shimoji, T.; Tanizawa, Y.; Sawamura, C.; Gokita, T.; Ae, K.; Kobayashi, H.; Sato, S. Orthopaedics 2010, 61, 859–863.

© 2019 by the authors. Licensee MDPI, Basel, Switzerland. This article is an open access article distributed under the terms and conditions of the Creative Commons Attribution (CC BY) license (http://creativecommons.org/licenses/by/4.0/).
Share and Cite
Aiba, H.; Hayashi, K.; Yamada, S.; Okamoto, H.; Kimura, H.; Miwa, S.; Inatani, H.; Otsuka, T.; Murakami, H. Treatment of a Malignant Soft Tissue Tumor Arising in the Vicinity of the Sciatic Nerve with an In-Situ Preparation Technique and Intensive Multidisciplinary Therapy. Cancers 2019, 11, 506. https://doi.org/10.3390/cancers11040506
Aiba H, Hayashi K, Yamada S, Okamoto H, Kimura H, Miwa S, Inatani H, Otsuka T, Murakami H. Treatment of a Malignant Soft Tissue Tumor Arising in the Vicinity of the Sciatic Nerve with an In-Situ Preparation Technique and Intensive Multidisciplinary Therapy. Cancers. 2019; 11(4):506. https://doi.org/10.3390/cancers11040506
Chicago/Turabian StyleAiba, Hisaki, Katsuhiro Hayashi, Satoshi Yamada, Hideki Okamoto, Hiroaki Kimura, Shinji Miwa, Hiroyuki Inatani, Takanobu Otsuka, and Hideki Murakami. 2019. "Treatment of a Malignant Soft Tissue Tumor Arising in the Vicinity of the Sciatic Nerve with an In-Situ Preparation Technique and Intensive Multidisciplinary Therapy" Cancers 11, no. 4: 506. https://doi.org/10.3390/cancers11040506
APA StyleAiba, H., Hayashi, K., Yamada, S., Okamoto, H., Kimura, H., Miwa, S., Inatani, H., Otsuka, T., & Murakami, H. (2019). Treatment of a Malignant Soft Tissue Tumor Arising in the Vicinity of the Sciatic Nerve with an In-Situ Preparation Technique and Intensive Multidisciplinary Therapy. Cancers, 11(4), 506. https://doi.org/10.3390/cancers11040506

